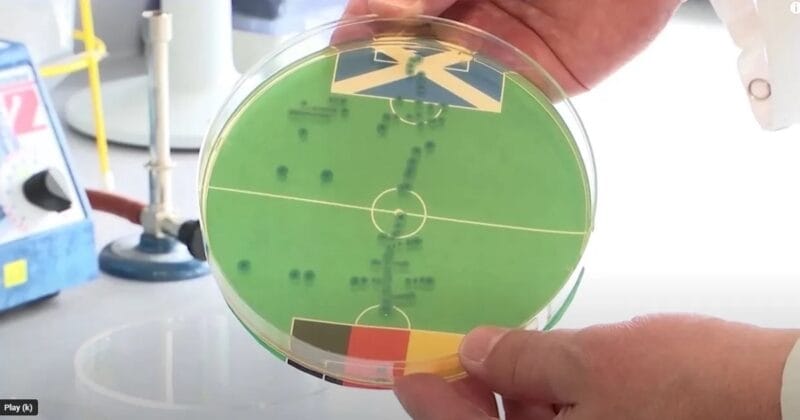
Vi khuẩn E. coli dự đoán ĐT Đức thắng trận mở màn Euro 2024

Một nhà khoa học người Đức đã dự đoán kết quả trận mở màn Euro 2024 giữa Đức và Scotland bằng cách sử dụng vi khuẩn E. coli.
Đến hẹn lại lên, mỗi kỳ giải đấu lớn được tổ chức, các hình thức dự đoán bắt đầu nở rộ. Người hâm mộ chắc không còn xa lạ với hình ảnh các con vật chọn ra đội chiến thắng. Tuy nhiên mới đây, nhà sinh vật học Markus Egert thậm chí đã sử dụng vi khuẩn để làm điều đó.
Vi khuẩn dự đoán trận mở màn Euro 2024
Thông qua tờ The Scottish Sun, Markus Egert lý giải: “Chúng tôi đã nuôi cấy vi khuẩn E. coli trên đĩa Petri với môi trường dinh dưỡng. Dựa vào sự phân bố của các khuẩn lạc, chúng tôi có thể dự đoán kết quả trận đấu bóng đá.”
Theo đó, ông đã dán hình ảnh một sân bóng thu nhỏ giữa ĐT Đức và ĐT Scotland lên đĩa nuôi cấy. Càng nhiều khuẩn lạc phát triển trong khu vực cấm địa của đội nào đồng nghĩa đội đó càng bị thủng lưới nhiều. Tin không vui cho người hâm mộ Scotland là vi khuẩn dự đoán chiến thắng nghiêng về đội chủ nhà Đức.
Ông Markus nói: “Đây là dự đoán cho trận mở màn giữa Đức và Scotland. Các bạn có thể thấy vi khuẩn phát triển nhiều hơn trong khu vực 16m50 của Scotland so với Đức. Điều này cho thấy Đức sẽ ghi nhiều bàn thắng hơn. Chúng tôi dự đoán một chiến thắng thuyết phục cho đội tuyển Đức.”
Thử thách cho nước chủ nhà
Trận khai mạc Euro 2024 sẽ diễn ra vào lúc 02h00 ngày 15/6 (theo giờ Việt Nam). Tất nhiên, “Cỗ xe tăng” Đức là những người được đánh giá cao hơn. Scotland chuẩn bị khá ổn cho hành trình Euro 2024 với chiến thắng 2-0 trước Gibraltar. Nhưng HLV Steve Clarke đang gặp khó khăn khi tiền đạo chủ lực Lyndon Dykes chấn thương.
Với việc xếp cùng bảng A với Scotland, Thụy Sĩ và Hungary, thầy trò HLV Julian Nagelsmann được dự đoán sẽ chiếm lĩnh ngôi đầu. Tuy nhiên, họ lại gây thất vọng trong trận giao hữu mới đây trước Ukraine. Dù tung ra đội hình rất chất lượng, nhưng Đức lại không thể chọc thủng lưới đối phương và chịu kết quả hòa 0-0.
5 Ứng Viên Vua Phá Lưới Euro 2024: Ronaldo Hạng 3, Kane Không Phải Số 1
Xem thêm: